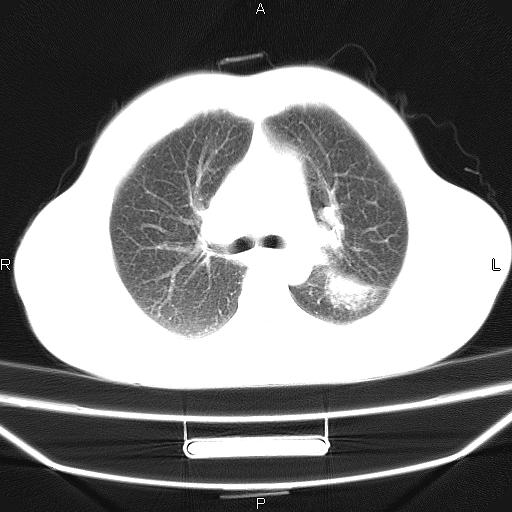

医影在线
标题: CT26599:男,40岁。间断发热,咳嗽二十余日。体温最高达38.9 [打印本页]
作者: xupengjie 时间: 2010-5-25 01:56
标题: CT26599:男,40岁。间断发热,咳嗽二十余日。体温最高达38.9
患者,男,40岁。间断发热,咳嗽二十余日。体温最高达38.9° 在当地诊所抗炎治疗三天后体温降至正常,患者自行停药。今又发热。胸片示,左下肺阴影。




















































[本贴已被 jiajie 于 2010-5-24 18:19:38 修改过]
作者: 学者~『风 时间: 2010-5-25 03:22
寄生虫感染?
作者: 听海观潮20 时间: 2010-5-25 04:12
标题: 左下肺片状高密度影
左下肺片状高密度影,境界模糊,密度不均,考虑感染性病变可能性大,建议抗炎治疗后复查。左肺门增大,不除外占位性病变,必要时支气管镜检。
[本贴已被 听海观潮2008 于 2010-5-24 20:14:49 修改过]
作者: 同 时间: 2010-5-25 04:50
考虑感染性病变可能性大,抗炎后复查,占位不排除。
作者: 卜一 时间: 2010-5-25 04:53
左下肺片状高密度影,境界模糊,密度不均,考虑感染性病变可能性大,建议抗炎治疗后复查。左肺门增大,不除外占位性病变,必要时支气管镜检。
支持!
作者: 施明 时间: 2010-5-25 05:15
炎症
作者: lechangzhongyi3 时间: 2010-5-25 05:19
考虑感染性病变可能性大,抗炎后复查,占位不排除。
作者: 随光逐影 时间: 2010-5-25 05:33
支持3楼意见。
作者: zsl6918 时间: 2010-5-25 05:38
建议强化或纤支镜观察,考虑肿瘤性病变可能性大
作者: yuhongjun 时间: 2010-5-25 18:18
考虑感染性病变可能性大,抗炎后复查,占位不排除。
作者: LIAOQIANG 时间: 2010-5-25 21:53
考虑感染性病变,不除外占位,建议抗炎后复查。
| 欢迎光临 医影在线 (http://bbs.radida.com/bbs/) |
Powered by Discuz! X3.2 |